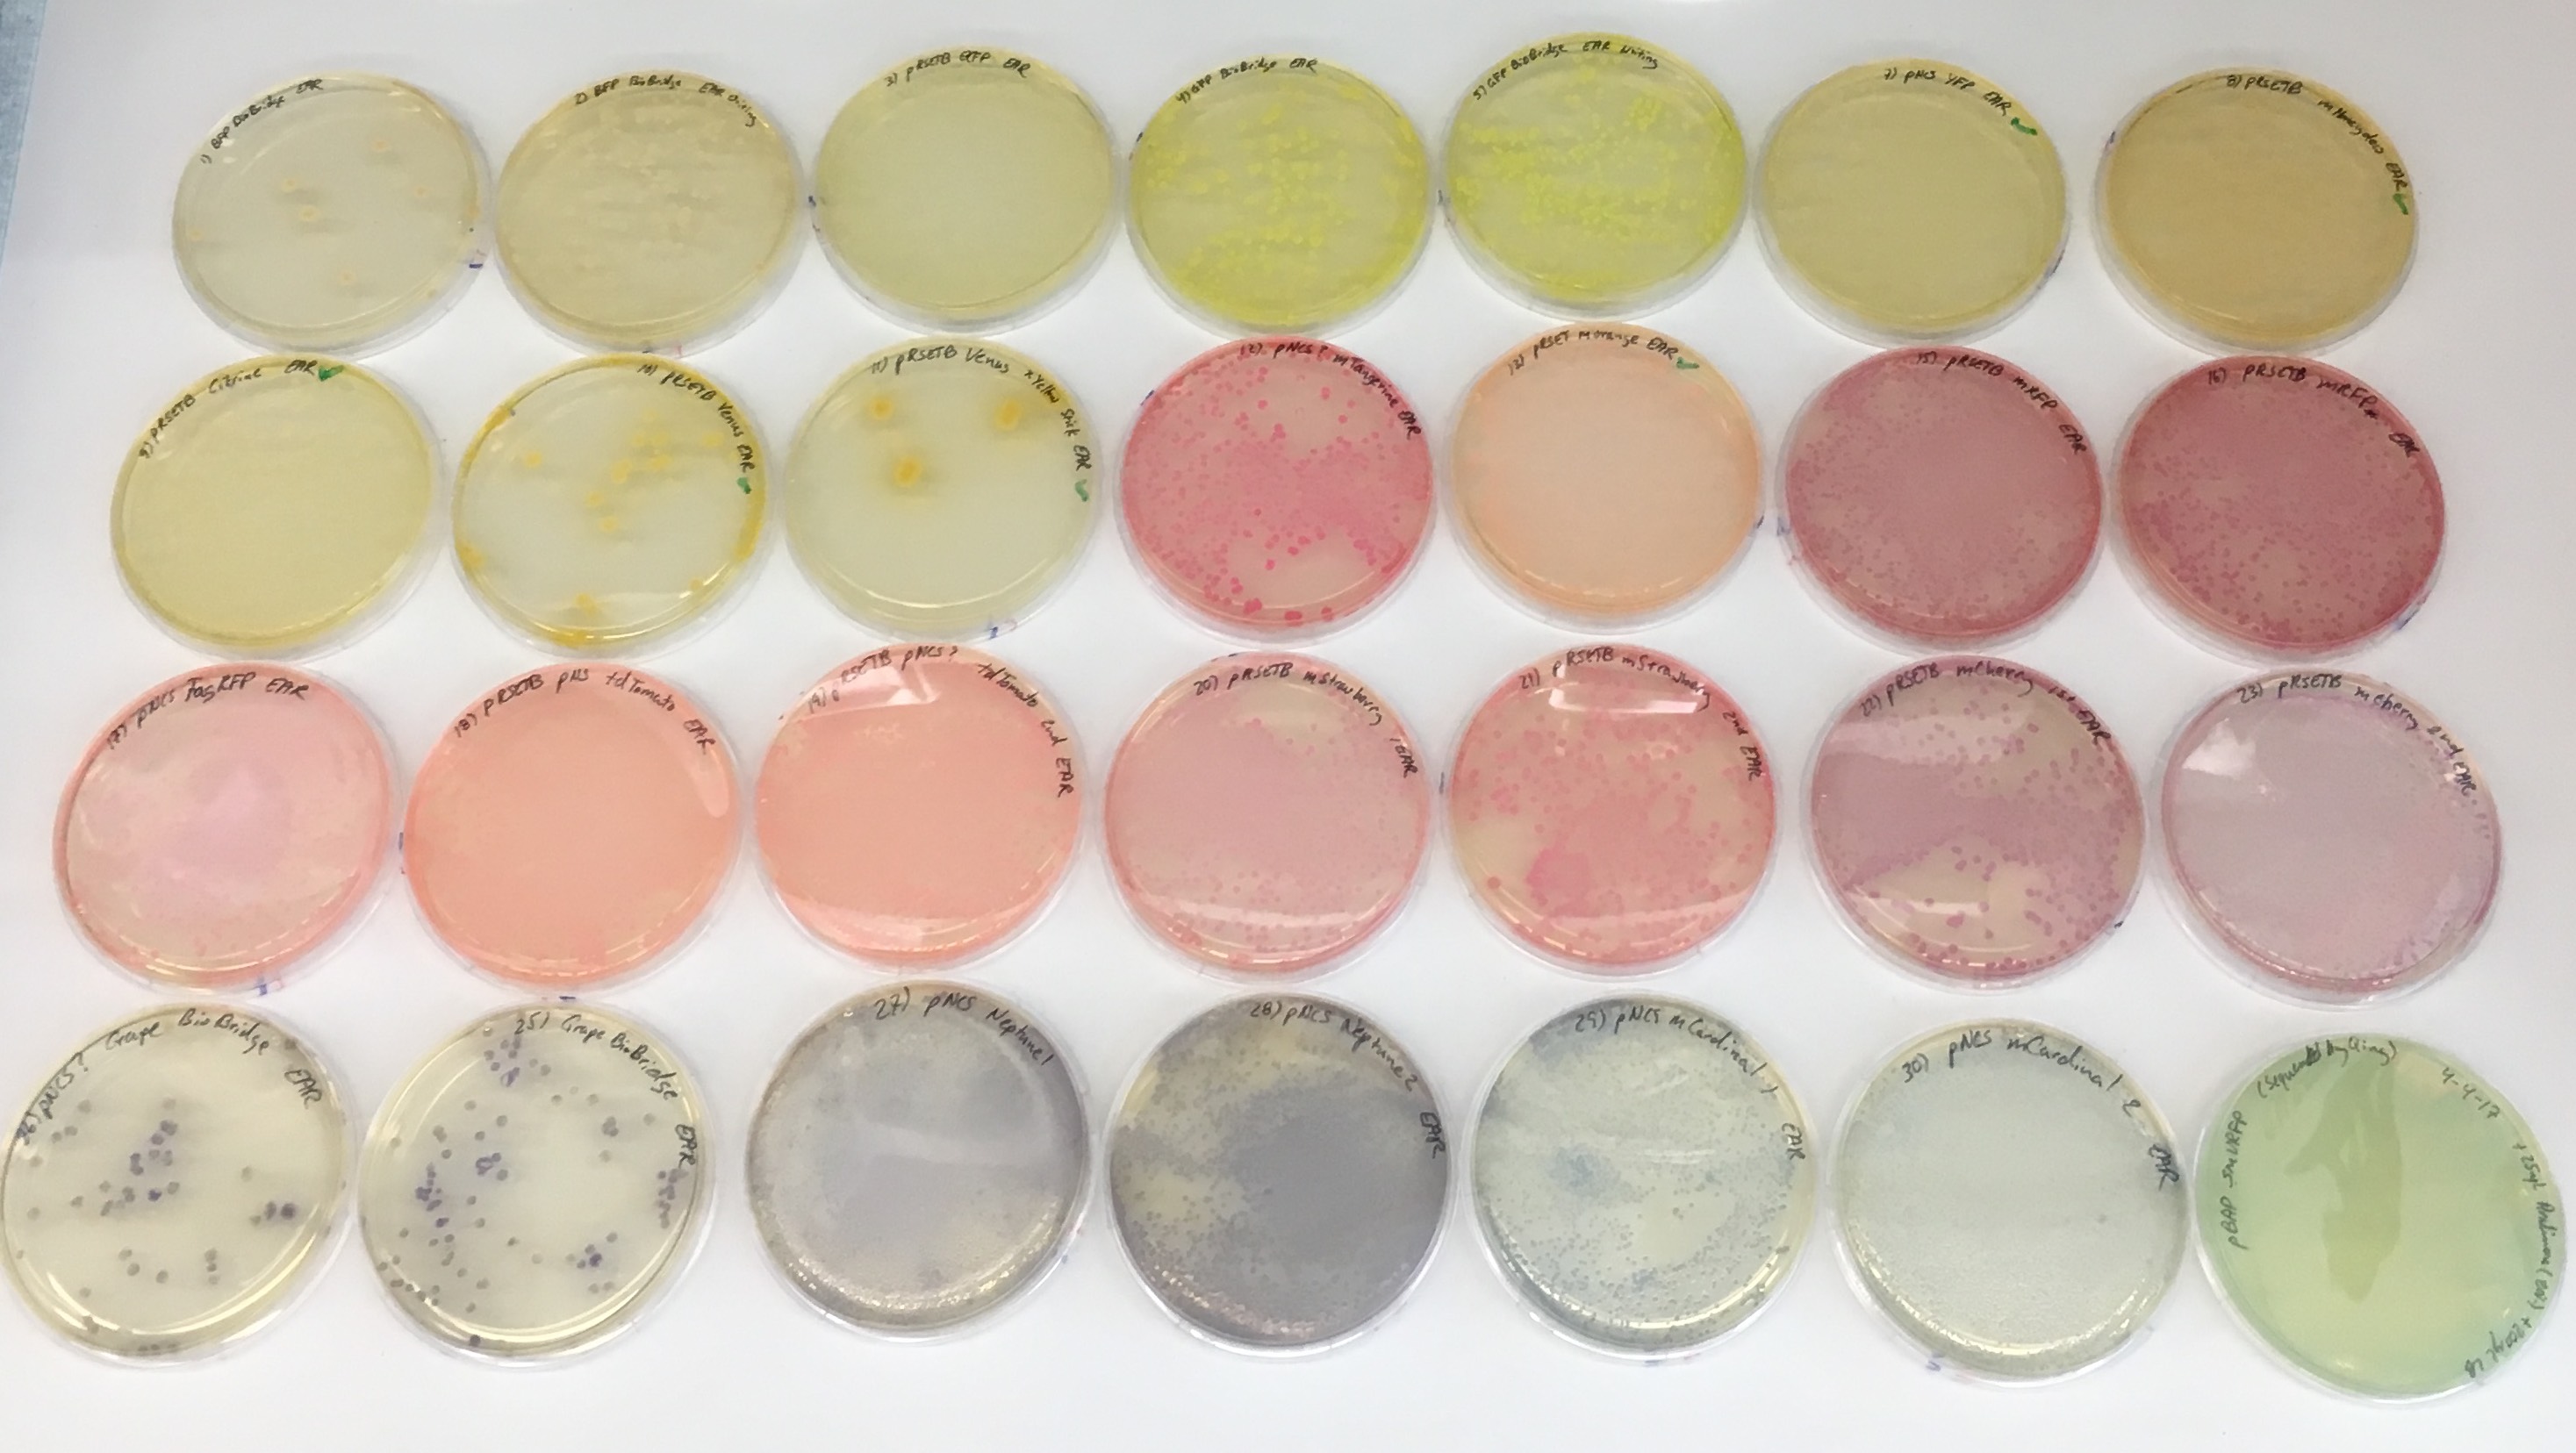

녹색 형광 단백질
"오늘의AI위키"의 AI를 통해 더욱 풍부하고 폭넓은 지식 경험을 누리세요.
1. 개요
녹색 형광 단백질(GFP)은 해파리에서 처음 발견된 단백질로, 특정 파장의 빛을 흡수하여 녹색 형광을 낸다. 11개의 베타 가닥으로 구성된 베타 병렬 구조를 가지며, 발색단인 HBI를 포함하는 알파 나선이 중앙을 통과하는 구조이다. GFP는 유전자와 융합하여 단백질의 위치 확인, 세포 내 메커니즘 및 운동성 연구, 유전자 발현 확인, 레포터 분석, 형광 현미경 등 생물학 연구에 널리 활용된다. GFP는 다양한 변형을 거쳐 청색, 청록색, 황색 등 다양한 색상의 형광 단백질로 개발되었으며, FMN 결합 형광 단백질(FbFPs)과 소형 초적색 형광 단백질(smURFP) 등 다양한 종류의 형광 단백질이 존재한다.
더 읽어볼만한 페이지
- 단백질 생합성에 관한 - 메틸화
메틸화는 메틸기를 분자에 첨가하는 과정으로, 생물학에서 유전자 발현 조절 등 생명현상에 관여하고 유기화학에서 유기 합성에 활용되며, 다양한 생물종에 존재하는 중요한 생리적 과정이다. - 생물 발광 - 생물발광
생물발광은 생물이 화학 반응을 통해 빛을 내는 현상으로, 산소, 루시페린, 루시페라아제 등이 관여하며, 의태, 유인, 통신 등 다양한 기능을 위해 진화했고, 해양 생물, 육상 생물 등 다양한 생물군에서 나타나며 생명공학 분야에도 활용된다. - 생물 발광 - 에쿼린
해파리에서 발견되는 생물발광 단백질인 에쿼린은 칼슘 이온과 결합하여 청색광을 방출하며 세포 내 칼슘 농도 측정에 사용되고, 녹색 형광 단백질 연구에 기여했으나, 기억력 보조제 성분으로 사용될 때 효능 논란과 허위 광고 혐의를 겪기도 했다.
녹색 형광 단백질 | |
---|---|
녹색 형광 단백질 | |
![]() | |
기호 | GFP |
이름 | 녹색 형광 단백질 |
Pfam | PF01353 |
Pfam 클랜 | CL0069 |
InterPro | IPR011584 |
SCOP | 1ema |
CATH | 1ema |
단백질 정보 | |
생물 | 아쿠오레아 빅토리아 |
UniProt | P42212 |
개요 | |
설명 | 자외선에 노출되면 밝은 녹색 형광을 내는 단백질이다. |
발견 | 오사무 시모무라, 프랭크 H. 존슨, 사이카 요시마사에 의해 해파리의 일종인 아쿠오레아 포르스칼레아에서 에쿼린과 함께 추출되었다. |
활용 | |
생물학 연구 | 단백질의 위치 및 상호 작용 연구에 사용된다. 유전자 치료에서 유전자 전달 모니터링에도 사용된다. |
특징 | 생체 발광을 이용한 연구에 사용된다. |
기타 | |
참고자료 | 연간 생화학 리뷰 형광 이미징의 기초 국립 지리학 웹사이트 |
2. 구조
GFP는 11개의 β-가닥으로 구성된 베타 병렬구조를 가지고 있으며, 주름진 시트 배열을 이룬다. 중앙에는 공유 결합된 발색단인 4-(''p''-하이드록시벤질리덴)이미다졸리딘-5-온(HBI)을 포함하는 α-나선이 통과한다.[3][40][41] 5개의 짧은 α-나선이 구조의 양 끝을 덮고 있다. 베타 병렬구조는 거의 완벽한 원통형으로, 길이 42Å, 지름 24Å이다(일부 연구에서는 지름이 30Å라고 보고했다).[14][40] 이것은 GFP 유사 단백질 계열에 고유한 "β-캔" 형태로 불린다.[41]
HBI는 트리펩타이드 Ser65–Tyr66–Gly67의 자발적으로 변형된 형태이며, 제대로 접힌 GFP 골격 없이는 형광을 나타내지 않는다. wtGFP에서 HBI는 주로 비이온화 페놀 형태로 존재한다.[42] 병렬구조 안쪽을 향한 측쇄는 Ser65–Tyr66–Gly67에서 특정 고리화 반응을 유도하여 HBI의 페놀레이트 형태로 이온화와 발색단 형성을 유도한다. 이러한 번역 후 변형 과정을 ''성숙''이라고 한다.[43] 수소 결합 네트워크와 이러한 측쇄와의 전자 스태킹 상호 작용은 GFP 및 수많은 유도체의 색상, 강도 및 광안정성에 영향을 미친다.[44] 밀집된 병렬구조는 용매 분자를 배제하여 물에 의한 발색단 형광의 소광을 방지한다. Ser65-Tyr66-Gly67의 자동 고리화 외에도 Tyr66 잔기에서 1,2-탈수소화 반응이 일어난다.[14]
발색단을 형성하는 세 가지 잔기 외에도 Gln94, Arg96, His148, Thr203 및 Glu222와 같은 잔기는 모두 안정제 역할을 한다. Gln94, Arg96 및 His148 잔기는 발색단 전하를 비편재화하여 안정화시킬 수 있다. Arg96은 HBI 고리에서 필요한 구조적 재정렬을 유도하기 때문에 가장 중요한 안정화 잔기이다. Arg96 잔기에 돌연변이가 발생하면 적절한 정전기적 및 입체적 상호 작용이 손실되어 발색단의 생성 속도가 감소한다. Tyr66은 수소 결합의 수용체이며, 유리한 정전기를 생성하기 위해 이온화되지 않는다.[45]
오완쿠라게의 생체 내에서는 애쿼린과 복합체를 형성하고 있다. 애쿼린은 단체로는 세포 내 칼슘을 감지하여 최대 형광 파장 460 nm의 청색 발광(생체발광)을 하지만, 오완쿠라게의 발색 세포 내에서는 GFP가 애쿼린으로부터 여기 에너지를 받아 최대 형광 파장 508 nm의 녹색 형광을 발한다(포스터형 에너지 전달). GFP의 녹색 형광 발색에 관해서는 시모무라 오사무의 일련의 연구에 의해 제창된 발색단의 분자 구조 모델을 기초로, 10년 이상 지난 1990년대에 들어서야 발색단의 분자 구조가 확인되었다. GFP 분자 내에서의 발색단의 형성에는 자기 탈수 결합만으로 충분하며, 효소 등 다른 분자의 도움을 필요로 하지 않는다.
GFP는 여기광을 비추면 단체로도 형광 발광(광발광)한다.
2. 1. 입체 구조
녹색 형광 단백질(GFP)은 238개의 아미노산으로 구성되며, 26.9kDa의 질량을 가진다.[3][40][41] 11개의 β-가닥은 베타 병렬구조를 이루며, 주름진 시트 배열을 형성한다. 중앙에는 공유 결합된 발색단인 4-(''p''-하이드록시벤질리덴)이미다졸리딘-5-온(HBI)을 포함하는 α-나선이 지나간다. 구조의 양 끝에는 5개의 짧은 α-나선이 덮고 있다.베타 병렬구조는 거의 완벽한 원통형으로, 길이 42Å, 지름 24Å(일부 연구에서는 30Å)이다.[14][40] 이는 GFP 유사 단백질 계열에 고유한 "β-캔" 형태라고 불린다.[41] HBI는 Ser65–Tyr66–Gly67 트리펩타이드의 자발적으로 변형된 형태이며, 제대로 접힌 GFP 골격 없이는 형광을 나타내지 않는다. wtGFP에서 HBI는 주로 비이온화 페놀 형태로 존재한다.[42]
병렬구조 안쪽을 향한 측쇄는 Ser65–Tyr66–Gly67에서 특정 고리화 반응을 유도하여 HBI의 페놀레이트 형태로의 이온화와 발색단 형성을 유도한다. 이러한 번역 후 변형 과정을 ''성숙''이라고 한다.[43] 수소 결합 네트워크와 이러한 측쇄와의 전자 스태킹 상호 작용은 GFP 및 그 유도체의 색상, 강도 및 광안정성에 영향을 미친다.[44] 밀집된 병렬구조는 용매 분자를 배제하여 물에 의한 발색단 형광의 소광을 방지한다. Ser65-Tyr66-Gly67의 자동 고리화 외에도 Tyr66 잔기에서 1,2-탈수소화 반응이 일어난다.[14]
발색단을 형성하는 세 잔기 외에도 Gln94, Arg96, His148, Thr203 및 Glu222와 같은 잔기는 모두 안정제 역할을 한다. Gln94, Arg96 및 His148 잔기는 발색단 전하를 비편재화하여 안정화시킬 수 있다. Arg96은 HBI 고리에서 필요한 구조적 재정렬을 유도하기 때문에 가장 중요한 안정화 잔기이다. Arg96 잔기에 돌연변이가 발생하면 적절한 정전기적 및 입체적 상호 작용이 손실되어 발색단의 생성 속도가 감소한다. Tyr66은 수소 결합의 수용체이며, 유리한 정전기를 생성하기 위해 이온화되지 않는다.[45]

2. 2. 형광체
녹색 형광 단백질(GFP)의 녹색 형광은 Ser65-Tyr66-Gly67에서 발광된다. Ser65-Tyr66-Gly67은 번역 후 변형 과정에서 1)접힘(folding), 2)고리화(cyclization), 3)탈수화(dehydrogenation), 4)산화(oxidation)의 과정을 통해 특징적인 형광체 구조로 변형된다.[43]
녹색 형광 단백질(GFP)은 1960년대와 1970년대에 시모무라 오사무가 빅토리아해파리에서 처음 발견했다.[9] 시모무라는 해파리에서 발광 단백질 아쿠오린과 함께 GFP를 정제하고 그 특성을 연구했다. 빅토리아해파리에서 GFP는 아쿠오린이 Ca2+ 이온과 반응하여 청색광을 낼 때, 이 에너지의 일부를 전달받아 녹색 형광을 낸다.[10]
GFP는 11개의 β-가닥으로 구성된 베타 병렬구조를 가지고 있으며, 주름진 시트 배열을 이루고 있다. 공유 결합된 발색단인 4-(''p''-하이드록시벤질리덴)이미다졸리딘-5-온(HBI)을 포함하는 α-나선이 중앙을 통과한다.[3][40][41] HBI는 트리펩타이드 Ser65–Tyr66–Gly67의 자발적으로 변형된 형태이며, 제대로 접힌 GFP 골격이 없으면 형광을 나타내지 않는다.[42] 병렬구조의 안쪽을 향한 측쇄는 Ser65–Tyr66–Gly67에서 특정 고리화 반응을 유도하여 HBI의 페놀레이트 형태로의 이온화와 발색단 형성을 유도한다. 수소 결합 네트워크와 이러한 측쇄와의 전자 스태킹 상호 작용은 GFP 및 수많은 유도체의 색상, 강도 및 광안정성에 영향을 미친다.[44] 밀집된 병렬구조는 용매 분자를 배제하여 물에 의한 발색단 형광의 소광을 방지한다. Ser65-Tyr66-Gly67의 자동 고리화 외에도 Tyr66 잔기에서 1,2-탈수소화 반응이 일어난다.[14] 발색단을 형성하는 세 가지 잔기 외에도 Gln94, Arg96, His148, Thr203 및 Glu222와 같은 잔기는 모두 안정제 역할을 한다. Gln94, Arg96 및 His148 잔기는 발색단 전하를 비편재화하여 안정화시킬 수 있다. Arg96은 HBI 고리에서 필요한 구조적 재정렬을 유도하기 때문에 가장 중요한 안정화 잔기이다.
3. 역사적 배경
오완쿠라게의 생체 내에서 GFP는 아쿠오린과 복합체를 형성한다. 아쿠오린은 단독으로 세포 내 칼슘을 감지하여 460 nm 파장의 청색 빛(생체발광)을 내지만, 오완쿠라게의 발색 세포 내에서는 GFP가 아쿠오린으로부터 여기 에너지를 받아 508 nm 파장의 녹색 형광을 방출한다(포스터형 에너지 전달). 시모무라의 연구를 바탕으로 GFP의 발색단 분자 구조 모델이 제시되었고, 10여 년 후인 1990년대에 그 구조가 실제로 확인되었다. GFP 분자 내에서 발색단은 효소 등의 도움 없이 자기 탈수 결합만으로 형성된다.
GFP는 외부에서 빛을 비추면 단독으로도 형광(광발광)을 낸다. 1990년대에 워드(Ward), 프래셔(Prasher) 등의 그룹이 GFP 유전자를 클로닝하는 데 성공했고[87], 챌피, 첸 등의 그룹이 형질전환 유전자 기술을 이용하여 다른 세포에 GFP를 도입하고 발현시키는 데 성공했다. 챌피와 첸은 시모무라와 함께 노벨 화학상을 수상했다. GFP는 기질을 필요로 하지 않고 단독으로 기능하며, 발색단 형성에 효소 반응이 필요 없다는 특징 덕분에 1990년대에 리포터 유전자로 널리 사용되기 시작했다.
3. 1. 야생형 GFP (wtGFP)
1960년대와 1970년대에, 녹색 형광 단백질(GFP)은 발광 단백질 아쿠오린과 함께 해파리 ''Aequorea victoria''에서 처음으로 정제되었고, 시모무라 오사무에 의해 그 특성이 연구되었다.[9] ''A. victoria''에서 GFP 형광은 아쿠오린이 Ca2+ 이온과 상호 작용하여 청색광을 유도할 때 발생한다. 이러한 발광 에너지의 일부는 GFP로 전달되어 전체 색상이 녹색으로 이동한다.[10]
오완쿠라게의 생체 내에서는 아쿠오린과 복합체를 형성하고 있다. 아쿠오린은 단체로는 세포 내 칼슘을 감지하여 최대 형광 파장 460 nm의 청색 발광(생체발광)을 하지만, 오완쿠라게의 발색 세포 내에서는 GFP가 아쿠오린으로부터 여기 에너지를 받아 최대 형광 파장 508 nm의 녹색 형광을 발한다(포스터형 에너지 전달). GFP의 녹색 형광 발색에 관해서는, 시모무라의 일련의 연구에 의해 제창된 발색단의 분자 구조 모델을 기초로, 10년 이상 지나 1990년대에 되어서야 발색단의 분자 구조가 확인되었다. GFP 분자 내에서의 발색단의 형성에는 자기 탈수 결합만으로 충분하며, 효소 등 다른 분자의 도움을 필요로 하지 않는다.
GFP는 여기광을 비추면 단체로도 형광 발광(광발광)한다. 시모무라에 의한 그 발견으로부터 30년 이상이 지난 1990년대, 워드(Ward)・프래셔(Prasher) 등의 그룹이 GFP 유전자의 동정・클로닝에 성공[87], 챌피, 첸 등의 그룹이 형질전환 유전자로서 이종 세포에 GFP 도입・발현에 성공했다(챌피 및 첸도 또한, 시모무라와 동시에 노벨 화학상을 수상하고 있다).
분자 생물학자들을 위한 도구로서의 유용성은 1992년 더글러스 프래셔가 ''Gene''에 wtGFP의 클로닝과 뉴클레오티드 서열을 보고할 때까지 인식되지 않았다.[11] 이 프로젝트의 자금이 소진되었기 때문에, 프래셔는 여러 실험실에 cDNA 샘플을 보냈다. 마틴 찰피의 실험실은 처음 몇 개의 아미노산이 삭제된 wtGFP의 코딩 서열을 ''E. coli''와 ''C. elegans''의 이종 세포에서 발현시켜 1994년 ''Science''에 결과를 발표했다.[12] 프레드릭 츠지의 실험실은 한 달 후 독자적으로 재조합 단백질의 발현을 보고했다.[13] 놀랍게도, GFP 분자는 해파리 특유의 외인성 보조인자 없이 실온에서 접히고 형광을 나타냈다. 이 거의 wtGFP에 가까운 형광 단백질은 형광을 띠었지만, 이중 피크 여기 스펙트럼, pH 민감성, 염화물 민감성, 낮은 형광 양자 수율, 낮은 광 안정성, 낮은 접힘 등 여러 가지 단점이 있었다.
최초로 보고된 GFP의 결정 구조는 1996년 ''Science''에서 Remington 그룹이 발표한 S65T 돌연변이체의 구조였다.[40] 한 달 후, Phillips 그룹은 ''Nature Biotechnology''에서 야생형 GFP 구조를 독립적으로 보고했다.[41] 이러한 결정 구조는 발색단 형성과 인접 잔기 상호 작용에 대한 중요한 배경을 제공했다.
GFP의 발색은 기질을 필요로 하지 않는 것과 단체로 기능하는 등의 특징으로부터, 또, 발색단 형성에 효소 반응이 필요 없는 것, 이종 세포에 대한 발현 방법이 확립된 것 등으로부터 1990년대에 리포터 유전자로서 널리 보급되었다.
3. 2. GFP 유도체
1990년대에 더글러스 프래셔 연구팀은 GFP 유전자를 동정하고 클로닝하는 데 성공했다.[87] 이후 마틴 챌피와 로저 첸 연구팀은 형질전환 유전자로서 이종 세포에 GFP를 도입하고 발현시키는 데 성공했다. GFP는 기질을 필요로 하지 않고 단독으로 기능하며, 발색단 형성에 효소 반응이 필요 없다는 특징 덕분에 1990년대에 리포터 유전자로 널리 사용되기 시작했다.
야생형 GFP를 바탕으로 형광 강도, 파장 특성, 최적 온도, 발색단 형성 속도 등이 개선된 다양한 개량형 GFP가 만들어졌다. 이러한 GFP 및 개량형 GFP는 세포 생물학, 발생 생물학, 신경 세포 생물학 등에서 가장 널리 사용되는 리포터 유전자가 되었다.
GFP는 실시간으로, 그리고 세포를 파괴하지 않고(in situla) 검출할 수 있으며, 다른 단백질과의 융합 단백질(GFP태그)로도 기능한다. 이러한 특징 덕분에 GFP는 세포 내 신호 전달 등에 관여하는 단백질의 세포 내 위치를 파악하는 데 필수적인 도구가 되었다. 다만, 실험 대상 단백질의 기능에 영향을 줄 가능성도 있으므로 결과 해석에 신중해야 한다.
광범위한 사용과 연구자들의 요구에 따라 다양한 GFP 돌연변이체가 개발되었다.[15][16] 1995년 로저 첸은 단일 점 돌연변이(S65T)를 통해 GFP의 분광 특성을 크게 향상시켰다.[17] 이 돌연변이로 형광 및 광안정성이 증가하고 주요 여기 피크가 488 nm로 이동했으며, 피크 방출은 509 nm로 유지되었다. 이는 FITC 필터 세트의 분광 특성과 일치하여 일반 연구자들이 사용하기에 더욱 편리해졌다. 1995년에는 37 °C 접힘 효율(F64L) 점 돌연변이를 통해 포유류 세포에서 GFP를 실용적으로 사용할 수 있게 하는 향상된 GFP(EGFP)가 개발되었다.[19] EGFP의 소광 계수(ε)는 55,000 M−1cm−1이며,[20] 형광 양자 수율(quantum yield)(QY)은 0.60이다. 상대 밝기(ε•QY)는 33,000 M−1cm−1이다.
2006년에는 잘 접히지 않는 펩타이드와 융합된 경우에도 GFP가 빠르게 접히고 성숙하도록 하는 일련의 돌연변이인 슈퍼폴더 GFP(sfGFP)가 보고되었다.[21]
청색 형광 단백질(EBFP, EBFP2, Azurite, mKalama1), 청록색 형광 단백질(ECFP, Cerulean, CyPet, mTurquoise2), 황색 형광 단백질(yellow fluorescent protein) 유도체(YFP, Citrine, Venus, YPet) 등 다양한 색상의 돌연변이체도 개발되었다. BFP 유도체(mKalama1 제외)는 Y66H 치환을 포함하며, 380 nm 근처의 자외선 영역에서 넓은 흡수대와 448 nm에서 최대 방출을 나타낸다.
Zn(II)와 Cu(II)에 우선적으로 결합하는 녹색 형광 단백질 돌연변이체(BFPms1)도 개발되었다.[22] BFPms1은 더 높은 양자 수율을 위한 BFP 발색단(Y66H), Y145F, 베타-배럴에 구멍을 만드는 H148G 및 용해도를 증가시키는 여러 돌연변이를 포함한다. Zn(II) 결합은 형광 강도를 증가시키는 반면, Cu(II) 결합은 형광을 소광시키고 흡광도 최대값을 379 nm에서 444 nm로 이동시킨다.
청록색 유도체의 Y66W 치환은 발색단이 페놀 성분이 아닌 인돌(indole)로 형성되도록 한다. 추가적인 돌연변이를 통해 밝기가 회복되었으며, Cerulean의 Y145A 및 H148D 돌연변이는 발색단을 더 평면적이고 안정적으로 만들어준다.[23] 추가적인 돌연변이 유발을 통해 양자 수율이 0.93인 mTurquoise2가 개발되었다.[24]
YFP 유도체의 적색 편이 파장은 T203Y 돌연변이에 의해 달성되며, 이는 치환된 티로신 잔기와 발색단 사이의 π-전자 스태킹 상호 작용 때문이다.[3] 이러한 분광 변이체는 포스터 공명 에너지 전달(FRET) 실험에 사용된다.
반합리적 돌연변이 유발을 통해 pH 감응성 돌연변이체인 pHluorins와 초월적 pHluorins가 개발되었다. 시냅토브레빈(synaptobrevin)에 표지된 pHluorins는 뉴런에서 시냅스 활동을 시각화하는 데 사용되었다.[25]
산화환원 감응성 GFP(roGFP)는 베타 배럴 구조에 시스테인을 도입하여 개발되었으며, 시스테인의 산화환원(redox) 상태에 따라 형광 특성이 달라진다.[26]
4. 생물학적 마커로서의 장점
녹색 형광 단백질(GFP)은 생물학 연구에서 특정 대상을 관찰하기 위한 표지자로 사용된다. GFP는 다음과 같은 특징 덕분에 널리 사용되는 수단이다.
- GFP는 짧은 단백질 조각으로, 단위체만으로도 형광 기능을 한다. 즉, 해파리에서 GFP 유전자 외에 형광을 내기 위한 추가 요소가 필요 없다. 대부분의 단백질은 작동을 위한 다른 효소가 필요하지만, GFP는 형광체만 있으면 기능하며, 반응을 위한 보조 인자도 필요하지 않아 다른 유전자에 쉽게 주입하여 형광 발현을 확인할 수 있다.[48][49]
- GFP는 살아있는 세포가 스스로 유전자를 발현하여 생성되므로 세포에 독성이 없다. 따라서 세포가 살아있는 상태에서 원하는 것을 관찰할 수 있다는 장점이 있다.
- GFP는 레포터 유전자로 사용될 수 있다. 예를 들어, GFP는 에탄올, ''p''-포름알데히드, 페놀, 트리클로산, 파라벤 등 다양한 화학 물질의 독성 수준을 측정하는 데 효과적이다. GFP는 숙주 세포에 영향을 미치지 않아 레포터 단백질로 적합하며, 외부 시각화 염색, ATP, 보조 인자가 필요 없다. 오염 물질 수준이 증가하면 형광과 세포 밀도가 모두 감소하여 세포 활동 감소를 나타낸다. GFP가 오염 물질 지표로 작용하는 메커니즘을 밝히기 위해 추가 연구가 필요하다.[50] GFP를 주입한 제브라피시는 GFP를 주입하지 않은 제브라피시보다 세포 스트레스를 인식하는 데 약 20배 더 민감하다.[51]
- GFP의 가장 큰 장점은 도입 방식에 따라 유전될 수 있어, 발현되는 세포와 조직에 대한 지속적인 연구가 가능하다는 점이다. GFP 시각화는 비침습적이며 청색광 조사만 필요하다. GFP 자체는 생물학적 과정을 방해하지 않지만, 관심 있는 단백질에 융합될 경우, 링커 설계에 주의해야 한다. 단량체로 사용될 경우 세포 전체에 쉽게 확산될 수 있다.[52]
- 오와ン크라게의 생체 내에서는 애쿼린과 복합체를 형성한다. 애쿼린은 단체로는 세포 내 칼슘을 감지하여 최대 형광 파장 460 nm의 청색 발광(생체발광)을 하지만, 오와ン크라게의 발색 세포 내에서는 GFP가 애쿼린으로부터 여기 에너지를 받아 최대 형광 파장 508 nm의 녹색 형광을 발한다(포스터형 에너지 전달). GFP 분자 내에서의 발색단 형성은 자기 탈수 결합만으로 충분하며, 효소 등 다른 분자의 도움을 필요로 하지 않는다.
- GFP는 여기광을 비추면 단체로도 형광 발광(광발광)한다. 1990년대에 워드(Ward), 프래셔(Prasher) 등의 그룹이 GFP 유전자를 클로닝하고,[87] 챌피, 첸 등의 그룹이 형질전환 유전자로서 이종 세포에 GFP 도입 및 발현에 성공했다. GFP는 기질을 필요로 하지 않고 단체로 기능하며, 발색단 형성에 효소 반응이 필요 없고, 이종 세포 발현 방법이 확립되어 1990년대에 리포터 유전자로 널리 보급되었다.
- 야생형 단백질을 기초로 유전자 공학에 의해 형광 강도, 파장 특성, 최적 온도, 발색단 형성 속도 등이 다른 다양한 개량형 GFP가 만들어졌다. GFP 및 개량형 GFP는 세포 생물학, 발생 생물학, 신경 세포 생물학 등에서 가장 널리 사용되는 리포터 유전자가 되었다.
- GFP는 실시간, 그리고 현장에서(in situ|인 시투la) 검출할 수 있으며, 다른 단백질과의 융합 단백질로서도 기능을 발휘한다(GFP태그)는 점에서, 특히 세포 내 신호 전달 등에 관여하는 단백질의 세포 내 국재를 명확히 하는 도구로서 중요해졌다. 단, 실험 대상 단백질의 기능에 영향을 줄 가능성이 있으므로 결과 해석에 신중해야 한다.
5. 이용 분야
녹색 형광 단백질(GFP)은 생물학의 거의 모든 분야에서 다양하게 활용된다. 연구 목적에 따라 GFP 이용 방법을 크게 4가지로 분류할 수 있다.
- '''레포터 유전자로 활용:''' GFP는 특정 유전자의 발현 여부를 확인하는 레포터 유전자로 사용될 수 있다.[48][49] 예를 들어, GFP는 에탄올, ''p''-포름알데히드, 페놀, 트리클로산, 파라벤 등 다양한 화학 물질의 독성 수준을 측정하는 환경 독성 지표로 활용될 수 있다.[50] 오염 물질 농도가 증가하면 GFP 형광과 세포 밀도가 모두 감소하여 세포 활동 감소를 나타낸다.
- '''형광 현미경을 이용한 세포 관찰:''' GFP와 그 유도체는 형광 현미경을 이용한 세포 관찰에 혁신을 가져왔다.[53] GFP는 FITC와 같은 작은 형광 분자에 비해 살아있는 세포에 대한 광독성이 적어, 형광 단백질로 표지된 단백질을 발현하는 세포를 장시간 관찰할 수 있게 해준다.
- '''동물에서 유전자 발현 확인:''' 형질전환 동물을 이용한 유전자 발현 연구에 GFP가 활용된다. 예를 들어, 인슐린 유전자를 발현하는 닭을 만들 때 GFP 유전자를 함께 넣어 형광 발현 여부로 유전자 삽입 성공 여부를 쉽게 확인할 수 있다. 최근에는 형질전환 형광 한우 송아지가 탄생하여, 소와 같은 큰 동물에서도 GFP 발현이 가능함을 보여주었다.[89]
- '''형광 자체를 이용:''' 드물지만, 형광 그 자체를 얻기 위해 GFP를 이용하기도 한다. 대한민국 농촌진흥청에서는 형광색 실을 뽑는 누에고치를 개발했다.[90]
이 외에도 GFP는 다음과 같은 다양한 분야에서 활용되고 있다.
- '''단백질의 공동국재(colocalization) 분석''': Split GFP 기법을 이용하여 두 단백질이 같은 위치에 존재하는지 확인할 수 있다.
- '''거시적 생물학적 과정 추적''': 바이러스 감염 확산 등을 GFP 표지법을 이용하여 추적할 수 있다.[72]
- '''형질전환 애완동물''': 알바와 같이 예술, 사회적 논평, 또는 상업적 목적으로 GFP 형질전환 동물이 만들어지기도 한다.
- '''예술 작품''': 줄리안 보스-안드레아(Julian Voss-Andreae)는 GFP 구조를 기반으로 한 조각 작품을 제작했다.
5. 1. 단백질의 위치 확인
위치를 확인하고자 하는 단백질 유전자를 녹색 형광 단백질과 연결해서 유전자를 조작해 주면 개체 내에서 특정 단백질이 어떤 모양으로 어디에 위치하는지를 알 수 있다. 예를 들어 액틴 프로모터 뒤에 녹색 형광 단백질을 넣어준 꼬마선충(''C.elegans'')을 보면 액틴의 가는 섬유가 녹색 형광으로 빛이 나는 모습을 형광 현미경 아래에서 관찰할 수 있다.
5. 2. 세포 내 물질의 메커니즘 및 운동성 확인
녹색 형광 단백질(GFP)의 가장 큰 장점은 살아있는 세포를 관찰할 수 있다는 것이다. 이전에는 특정 시점에 정지된 모습만 볼 수 있었지만, GFP는 단백질의 이동, 자극에 대한 반응 등 세포가 살아있어야만 알 수 있는 현상들을 보여준다.예를 들어, GFP는 다음과 같은 연구에 활용된다.
GFP와 유사하지만 ''Aequorea victoria''에서 유래하지 않은 단백질도 많다. (\[\[dsRed]], eqFP611, Dronpa, TagRFPs, KFP, EosFP/IrisFP, Dendra 등) 이들은 다른 생물체에서 유래했기 때문에 예상치 못한 발색단 형성 방식을 보이기도 한다. KFP와 같이 자연적으로 형광이 없거나 약한 단백질을 돌연변이시켜 형광을 띠게 만들기도 한다.[31] 서로 다른 형광 단백질을 활용하면, 한 발색단의 빛으로 다른 발색단을 활성화시켜 빛의 파장을 바꾸는 FRET 현상을 이용할 수 있다.[32]
FMN 결합 형광 단백질(FbFPs)은 2007년에 개발된 작고(11~16 kDa) 산소와 무관하게 형광을 내는 단백질이다. GFP와 달리 분자 산소 없이도 플라빈 발색단을 형성하므로, 혐기성 또는 저산소 조건에서 유용하다.[33]

빌리루빈을 포함하는 UnaG 등은 600nm 이상의 장파장, 또는 녹색에서 적색으로의 광전환 등 독특한 특성을 보인다.
2016년에는 시아노박테리아(''Trichodesmium erythraeum'')의 피코빌리단백질인 α-알로피코시아닌에서 유래한 소형 초적색 형광 단백질(smURFP)이 개발되었다. smURFP는 외부 단백질 없이 발색단 빌리베르딘을 자동촉매적으로 삽입하는 리아제이다.[34][35] 해파리와 산호 유래 GFP 유사 단백질은 산소가 필요하고 발색단 형성 시 과산화수소를 생성하지만,[36] smURFP는 산소와 과산화수소 없이 빌리베르딘을 사용한다. smURFP는 큰 몰 흡광 계수(180,000 M−1 cm−1)와 적당한 양자 수율(0.20)을 가져 eGFP와 비슷하며, 대부분의 산호 유래 적색/원적색 형광 단백질보다 약 2배 밝다. 스펙트럼 특성은 유기 염료 Cy5와 유사하다.[34][37]
새로운 형광 단백질과 응용에 대한 더 자세한 내용은 관련 리뷰를 참고할 수 있다.[38][39]
5. 3. 동물에서 유전자 발현 확인
녹색 형광 단백질(GFP) 관련 기사에서는 여러 실험동물에서 GFP 발현이 성공했다는 소식을 볼 수 있다. 이는 동물을 통해 생산하려는 유용한 유전자들의 발현 가능성을 보여준다. 예를 들어 체세포 복제를 통해 인슐린 유전자를 발현하는 닭을 만들 때, GFP 유전자를 함께 넣어 형광 발현 여부로 유전자 삽입 성공 여부를 쉽게 확인할 수 있다.[89]최근 충북대 동물바이오신약 장기개발사업단에서 형질전환 형광 한우 송아지를 탄생시켰다.[89] 이는 쥐, 닭, 물고기 등에서 GFP를 발현한 이전 연구와 달리, 소와 같은 큰 동물에서도 GFP 발현이 가능함을 보여준 첫 사례이다. 이로써 고가의 치료용 단백질을 더 우수한 품질로 생산할 수 있는 가능성이 열렸다.
5. 4. 형광 그 자체를 얻고자 하는 경우
형광 단백질은 생명공학 분야에서 다양하게 활용되는데, 형광 그 자체를 얻기 위한 경우는 상당히 예외적이다. 예를 들어 대한민국 농촌진흥청에서는 형광색 실을 뽑는 누에고치를 개발했다.[90]녹색 형광 단백질(GFP) 외에도 ''Aequorea victoria''에서 유래하지 않은 다양한 GFP 유사 단백질이 존재한다. dsRed, eqFP611, Dronpa, TagRFPs, KFP, EosFP/IrisFP, Dendra 등이 그 예시이다. 이들은 서로 다른 생물체에서 유래했기 때문에 예상치 못한 발색단 형성 방식을 보이기도 한다. KFP와 같이 자연 상태에서는 형광이 없거나 약한 단백질을 돌연변이시켜 형광을 띠게 만들기도 한다.[31] 서로 다른 스펙트럼 특성을 가진 GFP 유사 단백질을 활용하면, 한 발색단의 여기 스펙트럼을 이용해 다른 발색단에 에너지를 전달하여(FRET) 빛의 파장을 변환할 수 있다.[32]
FMN 결합 형광 단백질(FbFPs)은 2007년에 개발된, 청색광 수용체에서 유래한 11~16 kDa 크기의 작은 산소 독립적 형광 단백질 군이다. GFP와 달리 분자 산소 없이도 플라빈 발색단을 형성하고 결합할 수 있어 혐기성 또는 저산소 조건에서 유용하다.[33]
빌리루빈을 포함하는 UnaG와 같은 형광 단백질은 600nm 이상의 장파장 방출, 녹색에서 적색으로의 광전환 등 독특한 특성을 보인다. 이들은 적색과 녹색 빛 사이의 변환이 가능할 정도로 여기 및 방출 파장이 충분히 떨어져 있다.
시아노박테리아(''Trichodesmium erythraeum'')의 피코빌리단백질인 α-알로피코시아닌에서 유래한 새로운 형광 단백질은 2016년에 개발되어 소형 초적색 형광 단백질(smURFP)로 명명되었다. smURFP는 리아제라는 자동촉매 작용을 통해 외부 단백질 없이 발색단 빌리베르딘을 자체 삽입한다.[34][35] 해파리와 산호에서 유래한 GFP 유사 단백질은 산소가 필요하고 발색단 형성 시 과산화수소를 생성하지만,[36] smURFP는 산소와 과산화수소 없이 빌리베르딘을 발색단으로 사용한다. smURFP는 큰 몰 흡광 계수(180,000 M−1 cm−1)와 적당한 양자 수율(0.20)을 가져 생물물리학적 밝기가 eGFP와 비슷하며, 산호 유래 적색 또는 원적색 형광 단백질보다 약 2배 밝다. smURFP의 스펙트럼 특성은 유기 염료 Cy5와 유사하다.[34][37]
새로운 종류의 형광 단백질과 그 응용에 대한 더 자세한 내용은 관련 문헌을 참고할 수 있다.[38][39]
5. 5. 레포터 분석
녹색 형광 단백질(GFP)은 레포터 유전자로 사용될 수 있다.[48][49] 1990년대에 널리 보급되었으며, 세포 생물학, 발생 생물학, 신경 세포 생물학 등에서 가장 널리 사용되는 리포터 유전자 중 하나이다.예를 들어, GFP는 환경 독성 수준의 레포터로 사용될 수 있다. 이 단백질은 에탄올, ''p''-포름알데히드, 페놀, 트리클로산, 파라벤 등 다양한 화학 물질의 독성 수준을 측정하는 효과적인 방법으로 입증되었다. GFP는 숙주 세포에 도입되었을 때 아무런 영향을 미치지 않아 레포터 단백질로서 매우 적합하며, 외부 시각화 염색, ATP, 보조 인자 등이 필요 없다. 오염 물질 수준이 증가하면 형광과 세포 밀도가 모두 감소하여 세포 활동이 감소함을 나타낸다. GFP가 오염 물질 지표로 작용하는 메커니즘을 명확히 하기 위해 추가 연구가 필요하다.[50] GFP를 주입한 제브라피시는 GFP를 주입하지 않은 제브라피시보다 세포 스트레스를 인식하는 데 약 20배 더 민감하다는 유사한 결과가 관찰되었다.[51]
야생형 단백질을 기초로 유전자 공학을 통해 형광 강도, 파장 특성, 최적 온도, 발색단 형성 속도 등이 개선된 다양한 개량형 GFP가 만들어졌다.
GFP는 실시간, 그리고 현장(in situla, 세포 파괴 필요 없음)에서 검출 가능하며, 다른 단백질과의 융합 단백질(GFP태그)로도 기능하여 세포 내 신호 전달 등에 관여하는 단백질의 세포 내 국재를 명확히 하는 중요한 도구이다. 단, 실험 대상 단백질의 기능에 영향을 줄 가능성이 있으므로 결과 해석에 신중해야 한다(현재 이를 대체하는 저분자 시약도 개발되고 있다).
5. 6. 형광 현미경
GFP(녹색 형광 단백질)와 그 유도체의 등장은 형광 현미경과 세포생물학 및 기타 생물학 분야에서의 활용 방식을 완전히 재정의했다.[53] FITC(fluorescein isothiocyanate)와 같은 대부분의 작은 형광 분자는 살아있는 세포에 사용될 때 강한 광독성을 나타내지만, GFP와 같은 형광 단백질은 살아있는 세포에서 조명을 받을 때 일반적으로 훨씬 해롭지 않다. 이는 고도로 자동화된 생세포 형광 현미경 시스템의 개발을 촉진했으며, 이 시스템은 형광 단백질로 표지된 하나 이상의 단백질을 발현하는 세포를 시간 경과에 따라 관찰하는 데 사용할 수 있다.생세포 이미징 실험에서 GFP를 활용하는 방법은 많다. 가장 직접적인 방법은 관심 단백질에 직접 부착하는 것이다. 예를 들어, GFP는 관심 유전자의 성공적인 형질감염을 나타내기 위해 다른 유전자를 발현하는 플라스미드에 포함될 수 있다. 또 다른 방법은 시간이 지남에 따라 형광이 녹색에서 노란색으로 변하는 돌연변이를 포함하는 GFP를 사용하는 것이다. 이는 형광 타이머라고 한다. 형광 타이머를 사용하여 연구자들은 형광 단백질이 보고하는 색상을 기반으로 최근에 활성화된, 지속적으로 활성화된 또는 최근에 비활성화된 단백질 생성 상태를 연구할 수 있다.[54] 또 다른 예로, 과학자들은 GFP를 수정하여 방사선 조사 후에만 활성화되도록 하여 연구자들에게 세포의 특정 부분을 선택적으로 활성화하고 GFP로 표지된 단백질이 시작 위치에서 어디로 이동하는지 관찰할 수 있는 도구를 제공했다.[55] 이들은 급증하는 형광 현미경 분야의 두 가지 예일 뿐이며, GFP 및 기타 형광 단백질을 활용하는 바이오센서에 대한 더 자세한 검토는 여기에서 찾을 수 있다.[56]
예를 들어, GFP는 다양한 유기체의 정자에 표지하여 식별 목적으로 널리 사용되어 왔다. ''초파리''에서 GFP의 발현은 특정 특성의 마커로 사용될 수 있다. GFP는 또한 형태학적 구별이 가능하도록 다른 구조에서 발현될 수 있다. 이러한 경우, GFP 생성 유전자는 표적 단백질을 코딩하는 DNA 영역의 유기체 게놈에 통합되고 동일한 조절 서열에 의해 제어된다. 즉, 유전자의 조절 서열은 이제 표지된 단백질 외에도 GFP의 생성을 제어한다. 유전자가 발현되고 표지된 단백질이 생성되는 세포에서 GFP는 동시에 생성된다. 따라서 표지된 유전자가 발현되거나 표적 단백질이 생성되는 세포만 형광 현미경으로 관찰할 때 형광을 낸다. 이러한 타임랩스 영상 분석은 과거에는 고정된(즉, 죽은) 물질을 사용하여 연구되었던 단백질 접힘, 단백질 수송 및 RNA 역학을 포함한 많은 생물학적 과정에 대한 이해를 재정의했다. 얻어진 데이터는 세포 내 시스템의 수학적 모델을 보정하고 유전자 발현 속도를 추정하는 데에도 사용된다.[57] 마찬가지로, GFP는 이종 시스템에서 단백질 발현의 지표로 사용될 수 있다. 이 시나리오에서는 GFP를 포함하는 융합 단백질이 구조체의 RNA를 사용하여 간접적으로 또는 표지된 단백질 자체를 사용하여 직접적으로 도입된다. 이 방법은 형광 현미경을 사용하여 거대 분자 또는 단일 분자 규모에서 표지된 단백질의 구조적 및 기능적 특성을 연구하는 데 유용하다.
SPDM Phymod 기술을 사용하는 Vertico SMI 현미경은 GFP 및 그 유도체와 같은 형광 염료의 소위 "가역적 광표백" 효과를 사용하여 10 nm의 광학 해상도로 단일 분자로 국재화한다. 이것은 두 개의 GFP 유도체의 공동 국재화(2CLM)로도 수행될 수 있다.[58]
GFP의 또 다른 강력한 용도는 특정 세포의 작은 집합에서 단백질을 발현하는 것이다. 이를 통해 연구자는 배양 접시에서(''in vitro'') 또는 심지어 살아있는 유기체에서(''in vivo'') 특정 유형의 세포를 광학적으로 감지할 수 있다.[59] 여러 분광 변형체의 GFP를 유전적으로 결합하는 것은 뇌 회로 분석에 유용한 방법이다(Brainbow).[60] 문헌에서 형광 단백질의 다른 흥미로운 용도로는 FP를 뉴런 막전위 센서로 사용하는 것,[61] 세포막에서 AMPA 수용체 추적,[62] 바이러스 침입 및 개별 인플루엔자 바이러스 및 렌티바이러스의 감염 등이 있다.[63][64]
또한 새로운 형질전환 GFP 랫트 계통이 유전자 치료와 재생 의학에도 관련이 있음이 밝혀졌다.[65] "고발현체" GFP를 사용하여 형질전환 랫트는 대부분의 조직에서 높은 발현을 나타내며, 이전 GFP 형질전환 랫트에서는 특성이 규명되지 않았거나 부분적으로만 규명된 많은 세포를 보여준다.
GFP는 저온생물학에서 생존력 분석으로 유용한 것으로 나타났다. 트립판 블루 분석으로 측정한 생존력과의 상관 관계는 0.97이었다.[66] 또 다른 응용 분야는 포유류 세포에서 형질감염 효율에 대한 내부 대조군으로 GFP 공동 형질감염을 사용하는 것이다.[67]
GFP의 새로운 가능한 용도에는 인간 배아 신장 세포주로 만들어진 eGFP 레이저 시스템을 통해 세포 내 과정을 민감하게 모니터링하는 것이 포함된다. 최초의 공학적 생체 레이저는 반사 광학 공진기 내부에 있는 eGFP를 발현하는 세포로 만들어지며 청색광 펄스로 조사된다. 특정 펄스 임계값에서 eGFP의 광학 출력은 더 밝아지고 파장 516 nm의 순수 녹색의 색상이 완전히 균일해진다. 레이저 광으로 방출되기 전에 빛은 공진기 내부에서 앞뒤로 반사되고 세포를 여러 번 통과한다. 광학 활동의 변화를 연구함으로써 연구자들은 세포 과정을 더 잘 이해할 수 있다.[68][69]
GFP는 암 세포를 표지하고 추적하기 위해 암 연구에서 널리 사용된다. GFP로 표지된 암 세포는 암 세포가 먼 기관으로 전이되는 과정인 전이를 모델링하는 데 사용되었다.[70]
5. 7. Split GFP
녹색 형광 단백질(GFP)은 단백질의 공동국재(colocalization)를 분석하는 데 사용될 수 있다. 이는 단백질을 자가 조립이 가능한 두 개의 단편으로 "분리"한 다음, 이들 각각을 관심 있는 두 개의 단백질에 융합하여 달성한다. 단독으로, 이러한 불완전한 GFP 단편은 형광을 낼 수 없다. 그러나 관심 있는 두 단백질이 공동국재하는 경우, 두 GFP 단편이 함께 조립되어 형광을 낼 수 있는 GFP 유사 구조를 형성한다. 따라서 형광 수준을 측정함으로써 관심 있는 두 단백질이 공동국재하는지 여부를 판별할 수 있다.[71]5. 8. 거시 사진
과거에는 돌연변이를 유발하는 자외선(UV)을 사용하여 생물체를 비추고 GFP 발현을 검출하여 사진을 찍었다.[73] 최근에는 돌연변이를 유발하지 않는 LED 조명을 사용해 거시 사진을 촬영하는 기술이 개발되었다.[74][75] 이 기술은 형광 현미경 제작에 사용되는 것과 동일한 원리를 기반으로 한 상측 형광 카메라 부착 장치를 사용한다.[76]
5. 9. 형질전환 애완동물
알바는 에두아르도 카크(Eduardo Kac)가 의뢰한 프랑스 연구소에서 예술과 사회적 논평을 목적으로 GFP를 이용해 만든 녹색 형광 토끼이다.[77] 미국의 요크타운 테크놀로지스(Yorktown Technologies)는 수질 오염 감지를 위해 처음 개발된 녹색 형광 제브라피시(글로피시)를 수족관에 판매하고 있다. 미국의 네온펫츠(NeonPets)는 녹색 형광 쥐를 애완동물 산업에 네온마우스(NeonMice)라는 이름으로 판매하고 있다.[78] 국립 타이완 대학교 동물 과학 기술학과 우 신치(Wu Shinn-Chih)가 이끄는 연구팀은 녹색 형광 돼지인 노엘(Noels)을 사육했다.[79] 일본과 미국의 공동 연구팀은 질병, 특히 HIV에 대한 모델 유기체로 활용할 가능성을 확인하기 위해 녹색 형광 고양이를 만들었다.[80] 2009년 서울대학교의 한국 연구팀은 해파리의 섬유아세포를 이용하여 최초의 형질전환 비글을 사육했다. 이 개들은 적색 형광을 발하며, 과학자들이 나르콜렙시와 실명과 같은 인간 질병을 유발하는 유전자를 연구할 수 있도록 설계되었다.[81]5. 10. 예술
독일 출신의 예술가 줄리안 보스-안드레아(Julian Voss-Andreae)는 "단백질 조각상"을 전문으로 제작했다.[82] 그중에는 높이 1.7m(약 약 1.52m 약 17.78cm)의 "녹색 형광 단백질"(2004)[83]과 높이 1.4m(약 약 1.22m 약 17.78cm)의 "강철 해파리"(2006) 등 녹색 형광 단백질(GFP)의 구조를 기반으로 한 조각품들이 있다. "강철 해파리" 조각품은 1962년 시모무라 오사무(Osamu Shimomura)가 GFP를 발견한 곳인 워싱턴 대학교(University of Washington)의 프라이데이 하버 연구소(Friday Harbor Laboratories)에 있다.[84]
6. 그 외의 형광 물질
녹색 형광 단백질(GFP)의 아미노산 중 일부분을 돌연변이시켜 다음과 같은 형광 단백질들을 만들 수 있다.
- 파랑 형광 단백질(BFP; Blue fluorescent protein)은 375nm를 흡수하고 435nm의 파장을 방출한다.
- 청록색 형광 단백질(CFP)은 425nm을 흡수하고 480nm을 방출한다. (하위 섹션에서 더 자세히 다룸)
- 녹색 형광 단백질(GFP; Green fluorescent protein)는 480nm를 흡수한다.
- 노랑 형광 단백질(YFP; Yellow fluorescent protein)은 540nm를 흡수하고 550nm를 방출한다.
6. 1. 청록색 형광 단백질 (CFP)
로저 첸(Roger Yonchien Tsien)이 청록색 형광 단백질(CFP)을 만들었다. 청록색 형광 단백질은 녹색형광단백질(GFP)을 돌연변이시켜 만든다. 녹색형광단백질(GFP)은 238개의 아미노산으로 이루어져 있는데, 그 중 65번째 아미노산인 세린(serine)이 트레오닌(threonine)으로 바뀌면 청록색 형광 단백질(CFP)이 만들어진다. 청록색 형광 단백질은 파란색 파장 영역대의 빛을 흡수하고 청록색 파장 영역의 빛을 내보낸다.참조
[1]
논문
Crystal structure of the Aequorea victoria green fluorescent protein
1996-09-00
[2]
논문
Chemical and physical properties of aequorin and the green fluorescent protein isolated from Aequorea forskålea
1978-08-00
[3]
논문
The green fluorescent protein
http://tsienlab.ucsd[...]
1998-00-00
[4]
서적
Fundamentals of Fluorescence Imaging
Jenny Stanford Publishing
[5]
논문
Fluorescent proteins as biomarkers and biosensors: throwing color lights on molecular and cellular processes
2008-08-00
[6]
논문
Green fluorescent protein—a bright idea for the study of bacterial protein localization
2001-10-00
[7]
서적
Gene Therapy of Cancer
2000-00-00
[8]
서적
Medical Cell Biology
Elsevier/Academic Press
2008-00-00
[9]
논문
Extraction, purification and properties of aequorin, a bioluminescent protein from the luminous hydromedusan, Aequorea
1962-06-00
[10]
논문
Intermolecular energy transfer in the bioluminescent system of Aequorea
1974-06-00
[11]
논문
Primary structure of the Aequorea victoria green-fluorescent protein
1992-02-00
[12]
논문
Green fluorescent protein as a marker for gene expression
1994-02-00
[13]
논문
Aequorea green fluorescent protein. Expression of the gene and fluorescence characteristics of the recombinant protein
1994-03-00
[14]
논문
Structural basis for dual excitation and photoisomerization of the ''Aequorea victoria'' green fluorescent protein
1997-03-00
[15]
논문
A guide to choosing fluorescent proteins
http://tsienlab.ucsd[...]
2005-12-00
[16]
서적
Fluorescent Analogs of Biomolecular Building Blocks: Design and Applications
Wiley
[17]
논문
Improved green fluorescence
http://tsienlab.ucsd[...]
1995-02-00
[18]
특허
Fluorescent Proteins
[19]
논문
FACS-optimized mutants of the green fluorescent protein (GFP)
1996-00-00
[20]
논문
Rapid purification of EGFP, EYFP, and ECFP with high yield and purity
2005-05-00
[21]
논문
Engineering and characterization of a superfolder green fluorescent protein
2006-01-00
[22]
논문
Structural chemistry of a green fluorescent protein Zn biosensor
2002-04-00
[23]
논문
Intrinsic dynamics in ECFP and Cerulean control fluorescence quantum yield
2009-10-00
[24]
논문
Structure-guided evolution of cyan fluorescent proteins towards a quantum yield of 93%
2012-00-00
[25]
논문
Visualizing secretion and synaptic transmission with pH-sensitive green fluorescent proteins
1998-07-00
[26]
논문
Investigating mitochondrial redox potential with redox-sensitive green fluorescent protein indicators
2004-03-00
[27]
논문
Partitioning of lipid-modified monomeric GFPs into membrane microdomains of live cells
2002-05-00
[28]
논문
The evolution of genes encoding for green fluorescent proteins: insights from cephalochordates (amphioxus)
2016-06-00
[29]
논문
Very bright green fluorescent proteins from the Pontellid copepod Pontella mimocerami
2010-07-00
[30]
웹사이트
eGFP
https://www.fpbase.o[...]
[31]
논문
Kindling fluorescent proteins for precise in vivo photolabeling
2003-02-00
[32]
논문
A Tandem Green-Red Heterodimeric Fluorescent Protein with High FRET Efficiency
2016-12-00
[33]
논문
Reporter proteins for in vivo fluorescence without oxygen
2007-04-00
[34]
논문
A far-red fluorescent protein evolved from a cyanobacterial phycobiliprotein
2016-09-00
[35]
서적
Fluorescent Proteins
Springer US
2023-00-00
[36]
논문
The green fluorescent protein
1998-01-01
[37]
논문
Structural and photophysical characterization of the small ultra-red fluorescent protein
2023-07-12
[38]
논문
The Growing and Glowing Toolbox of Fluorescent and Photoactive Proteins
2017-02-01
[39]
논문
Fluorescent proteins for in vivo imaging, where's the biliverdin?
2020-11-16
[40]
논문
Crystal structure of the Aequorea victoria green fluorescent protein
1996-09-01
[41]
논문
The molecular structure of green fluorescent protein
https://scholarship.[...]
1996-10-01
[42]
논문
Reversible denaturation of Aequorea green-fluorescent protein: physical separation and characterization of the renatured protein
1982-01-01
[43]
논문
Kinetic isotope effect studies on the de novo rate of chromophore formation in fast- and slow-maturing GFP variants
2008-09-01
[44]
논문
Fluorescent proteins and their applications in imaging living cells and tissues
2010-07-01
[45]
논문
Understanding the role of Arg96 in structure and stability of green fluorescent protein
2008-11-01
[46]
논문
The crystal structure of the Y66L variant of green fluorescent protein supports a cyclization-oxidation-dehydration mechanism for chromophore maturation
2004-04-01
[47]
논문
The mechanism of dehydration in chromophore maturation of wild-type green fluorescent protein: A theoretical study
2015-07-01
[48]
논문
Construction and use of a Cupriavidus necator H16 soluble hydrogenase promoter (PSH) fusion to gfp (green fluorescent protein)
2016-07-26
[49]
논문
Green fluorescent proteins in receptor research: an emerging tool for drug discovery
[50]
논문
Noninvasive monitoring of environmental toxicity through green fluorescent protein expressing Escherichia coli.
2016-04-01
[51]
논문
High-sensitivity real-time analysis of nanoparticle toxicity in green fluorescent protein-expressing zebrafish
2013-03-01
[52]
논문
GFP: Lighting up life
2009-06-01
[53]
논문
Fluorescence microscopy today
2005-12-01
[54]
논문
"Fluorescent timer": protein that changes color with time
2000-11-01
[55]
논문
A photoactivatable GFP for selective photolabeling of proteins and cells
2002-09-01
[56]
논문
Genetically encoded fluorescent biosensors illuminate kinase signaling in cancer
2019-10-01
[57]
논문
Using a single fluorescent reporter gene to infer half-life of extrinsic noise and other parameters of gene expression
2010-06-01
[58]
논문
Dual color localization microscopy of cellular nanostructures
https://hal.archives[...]
2009-06-01
[59]
논문
Fluorescent proteins as a toolkit for in vivo imaging
2005-12-01
[60]
논문
Transgenic strategies for combinatorial expression of fluorescent proteins in the nervous system
2007-11-01
[61]
논문
Genetically encoded fluorescent sensors of membrane potential
2008-08-01
[62]
논문
Photoinactivation of native AMPA receptors reveals their real-time trafficking
2005-12-01
[63]
논문
Visualizing infection of individual influenza viruses
2003-08-01
[64]
논문
Visualization of targeted transduction by engineered lentiviral vectors
2008-10-01
[65]
논문
New lines of GFP transgenic rats relevant for regenerative medicine and gene therapy
2010-10-01
[66]
논문
Green fluorescent protein: A novel viability assay for cryobiological applications
2000-06-01
[67]
논문
Computer-aided discovery, validation, and mechanistic characterization of novel neolignan activators of peroxisome proliferator-activated receptor gamma
2010-04-01
[68]
논문
Single-cell biological lasers
2011-01-01
[69]
논문
Green Fluorescent Protein Makes for Living Lasers
http://www.scientifi[...]
2011-06-13
[70]
논문
GATA-3 links tumor differentiation and dissemination in a luminal breast cancer model
2008-02-01
[71]
논문
Protein tagging and detection with engineered self-assembling fragments of green fluorescent protein
2005-01-01
[72]
논문
Progression of geminivirus-induced transgene silencing is associated with transgene methylation
2002-09-01
[73]
논문
Green fluorescent protein as a visual selection marker for papaya (Carica papaya L.) transformation
2004-04-01
[74]
논문
Non-invasive quantitative detection and applications of non-toxic, S65T-type green fluorescent protein in living plants
[75]
논문
An epifluorescent attachment improves whole-plant digital photography of Arabidopsis thaliana expressing red-shifted green fluorescent protein
2012-01-01
[76]
웹사이트
PlantEdDL - Using SRL digital cameras in quantitative investigations of plants expressing green fluorescent protein (GFP)
http://planted.botan[...]
2016-03-23
[77]
웹사이트
GFP Bunny
http://www.ekac.org/[...]
[78]
웹사이트
Glow-In-The Dark NeonMice
http://neonmice.com/
2016-08-30
[79]
뉴스
Scientists in Taiwan breed fluorescent green pigs
http://news.bbc.co.u[...]
[80]
논문
Antiviral restriction factor transgenesis in the domestic cat
2011-01-01
[81]
웹사이트
Fluorescent puppy is world's first transgenic dog
https://www.newscien[...]
[82]
논문
Protein Sculptures: Life's Building Blocks Inspire Art
2005-01-01
[83]
논문
Inspirierende Proteine
2005-01-01
[84]
웹사이트
Julian Voss-Andreae Sculpture
http://www.julianvos[...]
2007-06-14
[85]
논문
Extraction, purification and properties of aequorin, a bioluminescent protein from the luminous hydromedusan, Aequorea
[86]
웹사이트
ニュース - 科学&宇宙 - ノーベル化学賞はGFP発見者と開発者(記事全文)
http://www.nationalg[...]
ナショナルジオグラフィック 公式日本語サイト
2008-10-08
[87]
논문
Primary structure of the Aequorea victoria green-fluorescent protein
[88]
웹사이트
The Nobel Prize in Chemistry 2008
http://www.nobelpriz[...]
[89]
뉴스
충북대, 녹색 형광 단백질 한우 생산
http://news.donga.co[...]
[90]
뉴스
고부가 실크소재시대 열어갈 ‘형광누에’ 탄생 - 대한민국 농촌진흥청
http://www.rda.go.kr[...]
본 사이트는 AI가 위키백과와 뉴스 기사,정부 간행물,학술 논문등을 바탕으로 정보를 가공하여 제공하는 백과사전형 서비스입니다.
모든 문서는 AI에 의해 자동 생성되며, CC BY-SA 4.0 라이선스에 따라 이용할 수 있습니다.
하지만, 위키백과나 뉴스 기사 자체에 오류, 부정확한 정보, 또는 가짜 뉴스가 포함될 수 있으며, AI는 이러한 내용을 완벽하게 걸러내지 못할 수 있습니다.
따라서 제공되는 정보에 일부 오류나 편향이 있을 수 있으므로, 중요한 정보는 반드시 다른 출처를 통해 교차 검증하시기 바랍니다.
문의하기 : help@durumis.com